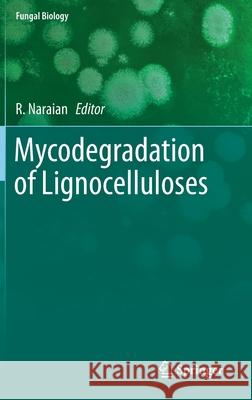
Mycodegradation of Lignocelluloses  9783030238339 Springer

» książki » Science - Life Sciences - Anatomy & Physiology
 |
Healing Orchids
ISBN: 9789811206443 / Angielski / Miękka / 152 str. Termin realizacji zamówienia: ok. 5-8 dni roboczych. |
cena:
171,42 |
|
Mycodegradation of Lignocelluloses
ISBN: 9783030238339 / Angielski / Twarda / 252 str. Termin realizacji zamówienia: ok. 5-8 dni roboczych. |
cena:
603,81 |
 |
Genetics and Genomics of Linum
ISBN: 9783030239633 / Angielski / Twarda / 270 str. Termin realizacji zamówienia: ok. 5-8 dni roboczych. |
cena:
603,81 |
 |
Stem Cells Heterogeneity in Different Organs
ISBN: 9783030241070 / Angielski / Twarda / 266 str. Termin realizacji zamówienia: ok. 5-8 dni roboczych. |
cena:
724,58 |
 |
Synthetic Seeds: Germplasm Regeneration, Preservation and Prospects
ISBN: 9783030246303 / Angielski / Twarda / 482 str. Termin realizacji zamówienia: ok. 5-8 dni roboczych. |
cena:
684,33 |
 |
Advances in Plant Transgenics: Methods and Applications
ISBN: 9789811396236 / Angielski / Twarda / 366 str. Termin realizacji zamówienia: ok. 5-8 dni roboczych. |
cena:
603,81 |
 |
Stem Cells and Aging: Methods and Protocols
ISBN: 9781493997121 / Angielski / Twarda / 354 str. Termin realizacji zamówienia: ok. 5-8 dni roboczych. |
cena:
684,33 |
 |
The Plant Stem: A Microscopic Aspect
ISBN: 9783030088057 / Angielski / Miękka / 207 str. Termin realizacji zamówienia: ok. 5-8 dni roboczych. |
cena:
201,24 |
 |
Recent Advancement in White Biotechnology Through Fungi: Volume 3: Perspective for Sustainable Environments
ISBN: 9783030255053 / Angielski / Twarda / 511 str. Termin realizacji zamówienia: ok. 5-8 dni roboczych. |
cena:
402,53 |
 |
Tolerance to Environmental Contaminants
ISBN: 9780367383114 / Angielski / Miękka / 464 str. Termin realizacji zamówienia: ok. 5-8 dni roboczych. |
cena:
323,20 |
 |
Methods in Insect Sensory Neuroscience
ISBN: 9780367393465 / Angielski / Miękka / 464 str. Termin realizacji zamówienia: ok. 5-8 dni roboczych. |
cena:
313,40 |
 |
Anatomy, Age and Ecology of High Mountain Plants in Ladakh, the Western Himalaya
ISBN: 9783030087661 / Angielski / Miękka / 616 str. Termin realizacji zamówienia: ok. 5-8 dni roboczych. |
cena:
1006,38 |
 |
Pollution of Water Bodies in Latin America: Impact of Contaminants on Species of Ecological Interest
ISBN: 9783030272951 / Angielski / Twarda / 366 str. Termin realizacji zamówienia: ok. 5-8 dni roboczych. |
cena:
402,53 |
 |
Osmoprotectant-Mediated Abiotic Stress Tolerance in Plants: Recent Advances and Future Perspectives
ISBN: 9783030274221 / Angielski / Twarda / 342 str. Termin realizacji zamówienia: ok. 5-8 dni roboczych. |
cena:
603,81 |
 |
Antibody-Drug Conjugates: Methods and Protocols
ISBN: 9781493999286 / Angielski / Twarda / 373 str. Termin realizacji zamówienia: ok. 5-8 dni roboczych. |
cena:
724,58 |
 |
Regenerative Medicine and Plastic Surgery
ISBN: 9783030296254 / Angielski / Twarda Termin realizacji zamówienia: ok. 5-8 dni roboczych. |
cena:
805,10 |
 |
Plant Physiological Ecology
ISBN: 9783030296384 / Angielski / Twarda / 736 str. Termin realizacji zamówienia: ok. 5-8 dni roboczych. |
cena:
442,79 |
 |
Current Trends in Biomedical Engineering and Bioimages Analysis: Proceedings of the 21st Polish Conference on Biocybernetics and Biomedical Engineerin
ISBN: 9783030298845 / Angielski / Miękka / 338 str. Termin realizacji zamówienia: ok. 5-8 dni roboczych. |
cena:
805,10 |
 |
Biomedical Statistics: A Beginner's Guide
ISBN: 9789813292932 / Angielski / Twarda / 287 str. Termin realizacji zamówienia: ok. 5-8 dni roboczych. |
cena:
342,14 |
 |
Orchid Biology: Recent Trends & Challenges
ISBN: 9789813294554 / Angielski / Twarda / 547 str. Termin realizacji zamówienia: ok. 5-8 dni roboczych. |
cena:
1127,15 |













